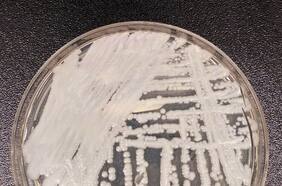
Nuevo hongo mortal Candida auris se expande peligrosamente: ¿quiénes son más susceptibles?

Centros para el Control y la Prevención de Enfermedades
19 JUNIO
Las medidas del secretario de Salud estadounidense Robert F. Kennedy Jr., generaron una crisis podría poner en riesgo la salud pública y aumentar muertes prevenibles en Estados Unidos, explicó una doctora experta en vacunas.
“Los estadounidenses van a morir”: la experta en vacunas que renunció por los ataques del gobierno de Trump
29 JULIO
03 ABRIL
Lo más leído
1.
3.